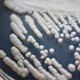

研究成果(プレスリリース)2021

2021年12月24日
硬くて柔らかいナノ多孔性材料が実現する室温核偏極
2021年12月24日
秩序と乱れが共存した高性能な液晶性有機半導体を開発

2021年12月23日
巨大な磁場応答を示す三角格子磁性半導体
2021年12月23日
接着剤いらずの超柔軟導電接合
2021年12月22日
世界初、ラックサイズで大規模光量子コンピュータを実現する基幹技術開発に成功
2021年12月22日
複雑な化学反応ネットワークを単純化する
2021年12月22日
塩基の代わりに酸を使うクロスカップリング反応
2021年12月21日
非標識の細胞形態情報をAIで高速に判別し、目的細胞を分取する技術を開発
2021年12月15日
植物の免疫応答を抑制する化合物を発見
2021年12月15日
次世代リプログラミング因子KLF4改変体の開発
2021年12月14日
強磁場発生装置を用いない量子抵抗標準素子の開発に成功
2021年12月13日
シグナル伝達複合体の2段階活性化
2021年12月10日
従来のスピン一重項・三重項の枠組みを超えた超伝導クーパー対状態の発見、その制御も可能に
2021年12月9日
ブラックホールが奏でる「普遍的な和音」
2021年12月9日
有機合成の難題である複雑な反応の機械学習・データ駆動型触媒設計による制御
2021年12月8日
新型コロナウイルスに殺傷効果を持つ記憶免疫キラーT細胞
2021年12月7日
ウイルスによる細胞のストレス応答抑制機構の解明
2021年12月7日
細胞がグルコース代謝量を制御する巧妙な仕組み
2021年12月6日
「誰を見てどう動いたか」理論とデータから推定できる機械学習技術を開発!
2021年12月2日
人工知能で酵素を自動設計
2021年12月2日
アストロサイトが担うシナプス制御メカニズムを発見
2021年12月2日
生命誕生初期のタンパク質を再現する試み
2021年12月2日
腸内細菌叢の状態を細胞画像から読み解く
2021年12月1日
橋梁の床版内部土砂化・滞水の新たな検知法
2021年12月1日
ステロイド関連大腿骨頭壊死症の発生に関わる遺伝子を同定
2021年11月26日
東南アジアのキャッサバ重要品種の形質転換系を開発
2021年11月25日
B型肝炎ウイルスは肝臓がんの染色体転座を引き起こす
2021年11月24日
室温で単一スキルミオンの電流駆動に成功
2021年11月23日
SPring-8-IIに向けSACLAを高性能入射器として利用
2021年11月19日
数十億枚のナノシートが協働する波運動
2021年11月19日
休眠をもたらす遺伝子の探索
2021年11月19日
磁石がつくる奇妙な光のねじれ現象
2021年11月18日
面直スピンによる有効磁場の発現
2021年11月18日
鉄シリコン化合物における新しいトポロジカル表面状態
2021年11月17日
タンパク質の連続的な合成を保証するリボソーム「トンネル」の役割を発見
2021年11月17日
新型コロナウイルス感染症治療薬の候補物質を発見
2021年11月17日
窒素固定を行うアナベナヘテロシストの光捕集機構を解明
2021年11月16日
遺伝性脳小血管病に対するカンデサルタンの有効性を確認
2021年11月15日
光で記憶を消去する
2021年11月12日
難消化性デンプンを豊富に合成するキャッサバ植物の開発
2021年11月12日
原発性免疫不全症の新しい原因遺伝子変異を同定
2021年11月12日
磁石の中の竜巻(スキルミオンひも)の三次元形状の可視化に成功
2021年11月11日
新たな大理石骨病とその原因遺伝子を発見
2021年11月11日
迅速な自己修復性を示す機能性材料の開発に成功
2021年11月10日
GABAを標的とする抗腫瘍免疫機構
2021年11月10日
小脳の大規模可視化に成功
2021年11月10日
指定難病に関わるタンパク質が脂質の二重層内移動を促進
2021年11月9日
アルツハイマー病の新しい治療標的を発見
2021年11月5日
植物の組織修復と接ぎ木における器官再接着に必要な転写因子を発見
2021年11月5日
熱の流れに量子効果が与える影響の解明
2021年10月28日
VATER症候群に類似する新規モデルマウスの作製に成功
2021年10月27日
上下動撹拌培養装置を用いた流体制御により誘導した反転型脳オルガノイド
2021年10月26日
非アルコール性脂肪性肝疾患悪化に歯周病原細菌による腸内環境への悪影響が関係する
2021年10月23日
リンが欠乏した植物の成長に必要な化合物を発見
2021年10月21日
マイクロ波と光のアンサンブル
2021年10月21日
環境低負荷な精密高分子合成に成功
2021年10月19日
電解水透析で重度の透析関連疲労感をほぼ消失
2021年10月19日
有機無機ペロブスカイトの光誘起構造変化を観測
2021年10月16日
ホロー原子を使ったX線レーザーの短パルス化
2021年10月15日
直接光子による陽子内グルーオンの運動の観測に成功
2021年10月14日
トポロジカルスピン構造から生じる磁気光学応答の観測に成功
2021年10月14日
超小型非破壊検査装置「中性子塩分計RANS-μ」を開発
2021年10月14日
分子の鎖を並べて柔らかい結晶を作る
2021年10月11日
小さな海馬CA2領域が記憶の固定に果たす大きな役割
2021年10月8日
常温・常圧で二酸化炭素の多孔性材料への変換に成功
2021年10月8日
熱帯雨林樹木“フタバガキ”の乾燥応答遺伝子の数が増加していた
2021年10月4日
国際バイオバンク連携によるヒト疾患リスク遺伝子アトラスを構築
2021年9月29日
最適な未来予想の実現化をモニターする神経細胞の発見
2021年9月29日
多成分結晶の新たな結晶化機構を発見
2021年9月28日
生体膜カルシウムイオン輸送の分子機構を解明
2021年9月27日
微小結晶からの高精度データ収集に最適な測定条件を提案
2021年9月21日
小児肝がん(肝芽腫)の発生機序を解明
2021年9月17日
がん抑制遺伝子の発現に影響を与える新しい遺伝子を発見
2021年9月17日
植物の多種共存を説明する新たなメカニズムの発見
2021年9月17日
AI制御によるクライオEMの自動測定システムを開発
2021年9月14日
ハイパー核の束縛エネルギー精密測定へ

2021年9月14日
イントロン由来の異常タンパク質が与えるストレス
2021年9月13日
高齢者 人付き合いの傾向で趣味活動の始めやすさに違いがある
2021年9月10日
鉄系超伝導体の超高速な結晶構造変化を実現
2021年9月10日
細胞用電動ナノ注射器「電気浸透流ナノポンプ」を開発
2021年9月9日
細胞分化におけるポリコム複合体の役割を解明
2021年9月8日
イソギンチャクの体の構造に“相称性の二刀流”を発見

2021年9月3日
植物の乾燥耐性とバイオマス生産性を高める化合物を発見
2021年9月3日
心筋症における異常RNAスプライシングの重要性を証明
2021年9月3日
新型コロナウイルス抗体を「その場」で測定
2021年9月3日
ナノスケールで整列する電子を可視化
2021年9月2日
たった1回の投薬で効く体内触媒戦法
2021年9月2日
単独で鉄を酸化も還元もできる微生物の発見
2021年9月2日
精子DNAを捨てないで
2021年9月1日
新しいメカニズムによる動的量子相転移を発見
2021年9月1日
超重元素の初めての精密質量測定に成功
2021年8月30日
変形性関節症の新しい遺伝子座位を56カ所発見
2021年8月30日
スパコンで予言する魅惑の新粒子「チャームダイオメガ」
2021年8月26日
第三世代アルツハイマー病モデルマウスの作製
2021年8月26日
陽子・反陽子の“離れ業”冷却
2021年8月24日
植物のアンモニウム毒性の原因を解明
2021年8月24日
乱れた量子系における粒子数揺らぎと量子もつれの成長則を発見
2021年8月23日
微小な熱流によるナノスケールスキルミオンの駆動に成功
2021年8月23日
3個以上のスピンが揃った多電子の読み出しに成功
2021年8月20日
植物の再生と防御のスイッチ

2021年8月19日
天然物が持つ鏡像異性な環状骨格を作り分ける
2021年8月19日
人工知能はゲノミクスで何を見つめるのか?

2021年8月19日
卵巣の加齢性変化を制御する遺伝因子
2021年8月19日
日本人の鼠径ヘルニア(脱腸)に関わる遺伝子座を同定
2021年8月19日
創発インダクタの室温動作を実証
2021年8月19日
1京分の3秒の分子応答
2021年8月13日
機械学習手法により物理の難問「量子スピン液体」を解明
2021年8月11日
アスパラガス成分に血圧降下作用があることを発見
2021年8月11日
X線ナノプローブスキャナーの発明
2021年8月10日
藻類細胞を電気的に高速形状判断するマイクロ流体デバイスを開発
2021年8月6日
熱と量子の揺らぎを発現する深層学習モデルを発見
2021年8月6日
植物の葉器官のサイズ制御の長年の謎を証明
2021年8月2日
行列推定の統計手法の数理
2021年8月2日
細胞シグナルを精密に制御する、スマートな人工細胞増殖因子の開発に成功
2021年8月2日
生体蛍光イメージングのための短波赤外蛍光色素
2021年8月2日
マウスの比較に基づく視覚情報の弁別
2021年7月30日
体の左右非対称性はmRNAの分解から始まる
2021年7月30日
精密な分子標的型抗がん剤の開発
2021年7月30日
腸内細菌から産生される健康長寿に関わる胆汁酸
2021年7月29日
水陸両生の水草ミズハコベが姿を変える仕組みを解明
2021年7月29日
視覚情報と自身の運動情報を脳内で弁別する仕組みを発見
2021年7月28日
人工クモ糸の物性を劇的に改善する新物質を発見
2021年7月28日
アルツハイマー病のタンパク質凝集体の構造の違いに迫る
2021年7月26日
最先端超伝導検出器で探るミュオン原子形成過程の全貌
2021年7月26日
胆道がんのゲノム医療拡大
2021年7月26日
脳の萎縮のメカニズムを解明
2021年7月22日
細胞の動きを制御するタンパク質の巧妙な仕組み
2021年7月22日
有袋類の遺伝子改変に世界で初めて成功
2021年7月21日
植物が生長とストレス応答を切り換える仕組みを解明
2021年7月21日
水のナノメートル空間で現れる特殊なダイナミクス
2021年7月16日
天体衝突を記録する結晶の生成を超高速計測
2021年7月16日
金属触媒で“変身”する保護基
2021年7月16日
単純立方格子状に自己集合するコロイド半導体量子ドット
2021年7月16日
マウス多能性幹細胞から機能的な卵巣組織の再生に世界で初めて成功!
2021年7月15日
ワクチンと感染では作られる抗体の質が異なることを発見
2021年7月15日
ヒストンメチル化による自閉症の新しいメカニズムを発見
2021年7月15日
酢酸による免疫グロブリンAの機能制御
2021年7月13日
卵母細胞の老化を1細胞で捉える
2021年7月12日
遺伝子の構造が「密」になると遺伝子の働きが抑制される
2021年7月12日
ハクサイの遺伝子発現調節機構を解明
2021年7月12日
膨大なメタゲノムデータの相同性検索を可能にするシステム「PZLAST」
2021年7月12日
惑星の母天体、実は長生き?
2021年7月10日
小麦による食物アレルギーのリスク因子を発見
2021年7月9日
クローン性造血の臨床予後への影響を解明

2021年7月9日
混雑した細胞内で薬はどう効くのか
2021年7月9日
オートファゴソームを効率よく作る仕組みを発見
2021年7月7日
対称か非対称か:細胞分裂パターンの二者択一

2021年7月7日
台風の強風予測を改善
2021年7月6日
発達障害の新規遺伝子を同定
2021年7月6日
父親の宇宙空間の滞在経験が子の遺伝子発現に影響する
2021年7月6日
エピゲノム異常に起因する脳機能不全の治療の可能性
2021年7月6日
非典型的開始コドンからの翻訳開始機構を解明
2021年7月5日
「超」高移動度、低電圧駆動できる有機半導体材料
2021年7月5日
紫外線照射による新型コロナウイルス不活化のメカニズム
2021年7月5日
ヒト希少遺伝疾患「NGLY1欠損症」発症機構の解明
2021年7月5日
寿命を制御する組織間相互作用
2021年7月2日
実験用マウスはメラトニンを合成できないので合成できるようにした
2021年7月2日
単一分子の精密ナノ分光
2021年6月30日
植物の小さなRNAが巨大なタンパク質合成装置の動きを止める
2021年6月30日
カニクイザルとコモンマーモセットの全ゲノム配列解読に成功
2021年6月30日
電池材料粒子内部の高精細な可視化に成功
2021年6月29日
軟X線顕微分光法による接着因子の可視化に成功
2021年6月29日
細胞は自ら通りやすい道を作り、その道を他の細胞も追随する
2021年6月28日
さまざまな材料表面を生理活性に
2021年6月28日
生命科学実験の効率的な自動化を実現するスケジューリング手法を開発
2021年6月25日
π骨格の表面合成と化学的同定
2021年6月24日
思春期特発性側弯症の発症・重症化予測モデルを開発
2021年6月23日
発達期に特定の樹状突起が選択的に強化される仕組みを解明
2021年6月22日
双極性障害に先天的・後天的デノボ変異がともに関連
2021年6月22日
新たな疾患発症メカニズムによる免疫不全症(AIOLOS異常症)の発見
2021年6月22日
脳の全細胞を解析するクラウドシステムの開発
2021年6月18日
体細胞モザイクはCOVID-19感染のリスクを高める
2021年6月17日
柔らかいスキルミオンの挙動を解明
2021年6月16日
三種の光を感知する新しい光受容体を発見
2021年6月16日
アブシシン酸の輸送を介した気孔開度の調節
2021年6月15日
遺伝性稀少疾患NGLY1欠損症の遺伝子治療法の可能性
2021年6月15日
「甘草」なのに「甘くない」のはなぜ?
2021年6月15日
マウス胎児の中に見つけた呼吸器再生のヒント
2021年6月11日
観測史上最古、131億年前の銀河に吹き荒れる超巨大ブラックホールの嵐
2021年6月10日
光捕集複合体フィコビリソームの単粒子構造解析
2021年6月10日
ジアステレオ収束的な(3+2)環化付加型反応の開発
2021年6月10日
脂質受容体の新たな活性化機構を解明
2021年6月10日
毛包幹細胞の発生起源を解明
2021年6月9日
植物病原菌の宿主を決める因子の発見
2021年6月9日
アトピー性皮膚炎発症の新しい遺伝因子

2021年6月8日
ナノカプセルを利用した植物ゲノム編集
2021年6月8日
シリコン3量子ビットを実現
2021年6月7日
DNAが酵素活性を増強する新機能の発見
2021年6月4日
動く分子と動かない分子が協調して、安定した位置情報を素早く作り出す
2021年6月3日
肥満が歯周病を悪化させる仕組みを解明
2021年6月3日
触媒活性理論の実証に前進
2021年6月2日
危険を冒して子を助ける親の脳
2021年6月1日
最も詳細な解像度でゲノムDNAの3次元構造を導く技術
2021年5月28日
生体分子の動きを効率的に捉えるシミュレーション技術を開発
2021年5月28日
休眠状態の卵胞が目覚めるためのシグナル
2021年5月27日
お金の流れのネットワーク構造を世界で初めて解明
2021年5月26日
酸化亜鉛でスピン軌道相互作用と電子相関の共存を実証
2021年5月25日
原子精度で定義されたナノ物質を正確に配置
2021年5月25日
“誕生日タグづけ”マウスの脳画像データベース「NeuroGT」を公開
2021年5月25日
コムギの光合成は2段階の葉緑体発生過程を経て成立する
2021年5月25日
“負の圧力”で膨張した「液体金属」を直接観察
2021年5月25日
植物が硫黄栄養をリサイクルする経路を解明
2021年5月25日
“自然界”を効率的に学習する方法を開発
2021年5月21日
結晶の世界をのぞくニューラルネットワーク
2021年5月21日
スピン流を超簡単にon/offスイッチング
2021年5月19日
荷電対称性の破れを発見
2021年5月19日
遺伝子の転写制御に関わるRNAのマイクロ秒構造変化
2021年5月19日
植物が地上に繁栄できた鍵
2021年5月18日
試験管内で染色体を作る
2021年5月18日
微生物生態系の安定性を俯瞰できる新手法
2021年5月18日
温室効果・オゾン層破壊の原因である亜酸化窒素の生物的発生機構の解明
2021年5月18日
精子形成におけるDNAメチル化の役割を解明
2021年5月17日
高耐熱エポキシ樹脂の硬化メカニズムを解明
2021年5月17日
低酸素環境下で高い糖代謝を示すがん細胞の特徴を解明
2021年5月13日
均一温度環境における熱電発電を可能にするメタマテリアル熱電変換素子を提案
2021年5月12日
コヒーレント回折イメージングがワンショットで可能に
2021年5月11日
高密度な中性子物質の硬さの測定に初めて成功
2021年5月11日
ほとんどオスを産まないハチの謎を解明
2021年5月10日
異種組織を一体化する細胞外環境の特性を解明
2021年5月7日
テングザルのお腹から新種の乳酸菌を発見!「ラクトバチルス ナサリディス」と命名
2021年5月7日
離れていてもつながった電子の軌道運動の実証
2021年5月6日
半導体量子ビットの確率的テレポーテーションに成功
2021年4月30日
磁石のカイラリティを利用した自然旋光性の電場制御に成功
2021年4月30日
日本人てんかん発症に関わる新規遺伝子領域を発見
2021年4月30日
免疫の個人差をつかさどる遺伝子多型の機能カタログを作成
2021年4月30日
マイクロバイオーム解析のための推奨分析手法を開発
2021年4月30日
ひとつひとつの観測データが気象予測に与える影響を簡易に評価可能に
2021年4月28日
腸内細菌叢の複雑な脂質多様性を解明する手法を開発
2021年4月28日
非小細胞肺がんにおけるインテグリンα11を介するCAFの活性化機序を解明
2021年4月27日
何度も着脱可能なガラス基板の接着法
2021年4月27日
増えるべきか死ぬべきか、それががん化の分かれ道だ
2021年4月27日
マーモセットの遺伝子発現データベースを公開
2021年4月26日
三つの陽子の間にはたらく三体力へのアプローチ
2021年4月24日
世界初のマウス体内におけるタギング治療
2021年4月22日
129億年前から銀河は回転していた
2021年4月22日
大質量星の超新星エンジンをX線観測で解明
2021年4月20日
赤外光駆動型光合成をクライオ電顕で捉える
2021年4月20日
皮膚表皮細胞の細胞死過程を解明
2021年4月20日
脳の宇宙を捉える顕微鏡
2021年4月19日
新型コロナウイルスの超高感度・世界最速検出技術を開発
2021年4月19日
オートファジーによるmRNA分解の選択性を発見
2021年4月17日
光第二次高調波発生の磁場制御に成功
2021年4月16日
「理想の水素原子」で未知の物理現象を探索するミュオニウムのマイクロ波分光実験がスタート
2021年4月15日
トポロジカル反強磁性金属の超高速スピン反転を実証
2021年4月15日
トポロジカル反強磁性体において電気的に読み書き可能な信号の増強に成功
2021年4月14日
ベタインはキネシン分子モーターの機能低下による統合失調症様の症状を改善する
2021年4月14日
スピン流で電流の渦を作る
2021年4月14日
ヘム濃度センサータンパク質の作動機序を原子レベルで解明
2021年4月13日
ブタジエンのバイオ生産に初成功
2021年4月13日
5,061遺伝子のノックアウトマウスを整備
2021年4月13日
汎化能力を最大化する特徴抽出
2021年4月9日
宇宙の灯台「かにパルサー」に隠れていたX線のきらめき
2021年4月8日
肝臓再生の開始と停止の鍵を握る機械刺激
2021年4月8日
一細胞解析から細胞変換を読みとく
2021年4月8日
新たな1細胞RNA分画解読法の開発に成功
2021年4月7日
RNAウイルスの感染を阻害する既存薬の同定
2021年4月6日
新たな骨の難病とその原因遺伝子を発見
2021年4月6日
妊娠中の運動が胎盤を通じて子の肥満を防ぐ
2021年4月6日
老化による幹細胞のがん化機構の発見
2021年4月6日
卵の記憶は胎盤へ
2021年4月5日
酵母の果糖発酵と資化能力を再発見
2021年4月2日
電気的な偏りのない2次元結晶を重ねるだけで面内に電荷の偏りと光発電機能を実現
2021年3月31日
体内での環化付加反応によるがん化学療法
2021年3月30日
スプライシング調節化合物がもたらす新たな作用を発見
2021年3月26日
トランスゴルジ網における積荷選別様式を可視化
2021年3月25日
ナノグラフェンの二重らせん構造が電子回折で明らかに
2021年3月23日
X線自由電子レーザーで捉えた、光照射によるチャネルロドプシンの構造変化の過程
2021年3月23日
Gタンパク質共役受容体活性化の鍵となる仕組みを解明
2021年3月23日
光化学系IIの立体構造をクライオ電顕で高精度に決定
2021年3月22日
極低温での新しい量子相“混合バブル”を予言
2021年3月20日
高強度X線が引き起こす特殊な融解現象
2021年3月19日
惑星系の化学組成は誕生前から多様?
2021年3月19日
葉緑体との相互作用におけるミトコンドリア運動を発見
2021年3月19日
超伝導における疎と密のクロスオーバーを実現
2021年3月19日
急性骨髄性白血病の個別最適化治療へ一歩
2021年3月18日
がん細胞上で薬剤を化学合成
2021年3月15日
汗中乳酸から高出力を生み出す薄膜型ウェアラブルバイオ燃料電池アレイを開発
2021年3月12日
細胞外マトリックスの構築の仕組み
2021年3月12日
糖尿病網膜症発症に関わるゲノム領域を同定
2021年3月12日
統計学と人工知能で世界標準の遺伝子診断ガイドラインをカイゼンする
2021年3月10日
超薄板ガラスの作製法
2021年3月10日
量子コンピュータを用いたべき乗法
2021年3月8日
複数企業の社内データを産学で共有して新薬創出を加速する革新的な枠組みの構築に成功
2021年3月8日
低温下における量子もつれの新法則を発見
2021年3月4日
卵子のための染色体分配装置の調整
2021年3月3日
精神疾患に関与する新しい遺伝子発現調節系の発見
2021年3月3日
トポロジーの異なる絶縁体界面による高効率磁化制御
2021年3月2日
植物は概日時計因子によって低温ストレスに対する耐性を獲得している
2021年3月1日
医師の判断プロセスに学んだ緑内障の画像診断システム
2021年3月1日
ジャガイモの毒α-ソラニンはトマトの苦味成分から分岐進化した
2021年2月26日
植物フィトクロムAの構造変化を可視化
2021年2月26日
機能性ペプチドによる毛髪成長促進効果を発見
2021年2月26日
AR(強化現実)を用いた次世代型肘関節鏡手術の開発
2021年2月25日
次世代磁性材料:反強磁性体の持つ普遍的機能性の実証
2021年2月25日
陽子の中の反物質が持つ大きな非対称性の発見
2021年2月25日
開放隅角緑内障に関係する127の遺伝的変化を発見
2021年2月24日
Deep LearningとALS iPS細胞を用いた疾患予測テクノロジー
2021年2月22日
重水素で解き明かす脂肪酸の抗がん作用
2021年2月22日
胆のうがんのゲノム異常の解明
2021年2月19日
シアノバクテリアの普遍的内部構造を可視化
2021年2月18日
理論計算による高効率な磁気構造予測手法の開発に成功
2021年2月18日
新型コロナウイルス感染の分子機構を解明
2021年2月18日
原子1つの沈殿を調べる!
2021年2月17日
ホルミシス効果の獲得と継承を担う小分子RNA
2021年2月16日
環状ペプチドは立体構造を変えて細胞に入る
2021年2月16日
単一伝搬電子による初めての軌道量子ビット
2021年2月15日
分子スケールの能動的な水輸送機構の提案
2021年2月12日
シナプス間の競合のメカニズムを発見
2021年2月10日
周期的な毛包再生を可能とする上皮性幹細胞の増幅と特定
2021年2月10日
ネットワーク上の情報の流れをダイアグラムで表現する新理論を開発!
2021年2月10日
高分子化合物による細胞の凍結保護効果の機序を解明
2021年2月9日
ヒスチジン残基をpiメチル化する酵素を発見
2021年2月9日
水表面の光化学反応は水中の1万倍速く進む
2021年2月8日
微小金属らせんとテラヘルツ光との相互作用を可視化
2021年2月8日
微小管が生まれる分子メカニズムを解明
2021年2月6日
がん細胞1個から中分子薬剤の細胞膜透過性を評価
2021年2月5日
タンパク質の柔らかさを予測するAI
2021年2月4日
多くのブランドが多くの手段を駆使する複雑な市場競争を理解する
2021年2月4日
海馬による相対的な時間表現
2021年2月3日
様々なモノに適用可能なフレキシブル非破壊検査シートを開発
2021年2月2日
近赤外光を利用したハイパースペクトル画像から粘膜下腫瘍(GIST)を識別
2021年2月1日
全身性エリテマトーデスの発症に関わる遺伝子座を同定
2021年1月28日
実材料に近い形態の多結晶で価電子を可視化
2021年1月28日
テラヘルツ光により超高速に操られたトンネル電子が引き起こす発光を初観測
2021年1月26日
反強磁性体で世界最大の自発磁気効果をもつ低消費電力磁気メモリ材料
2021年1月26日
室温でアンチスキルミオンを示す新物質の発見
2021年1月25日
宇宙から飛来した隕石から新鉱物ポワリエライトを発見
2021年1月22日
惑星は恒星と同時に作られていく?
2021年1月21日
V字型二重スリットによる電子波干渉実験
2021年1月21日
スズ原子核の表面でアルファ粒子を発見
2021年1月18日
抗がん性成分を生産する植物チャボイナモリの全ゲノムを高精度に解読
2021年1月15日
赤ちゃんマグロの餌、ワムシの大型化に成功
2021年1月13日
固体中の電子の軌道を曲げる新しい機構の発見
2021年1月13日
深層学習を用いてクロマグロの卵のふ化予測に成功
2021年1月13日
超伝導転移端検出器TESを用いた蛍光XAFS分析に成功

2021年1月8日
スピンとバレーの新しい電荷中性流を発見
2021年1月6日
イネの初期成長を促進する因子を発見
2021年1月5日
原子層の積み木細工によるトポロジカル物質設計
